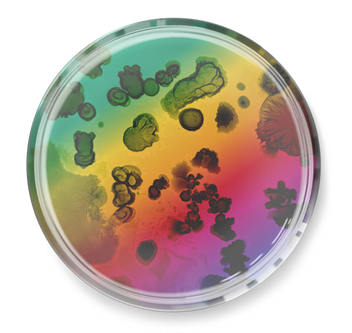
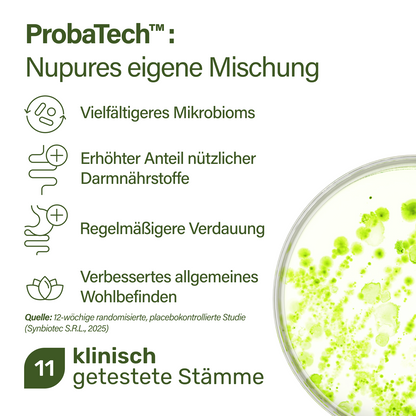
probaflor MAX SPEKTRUM N95 Pulver
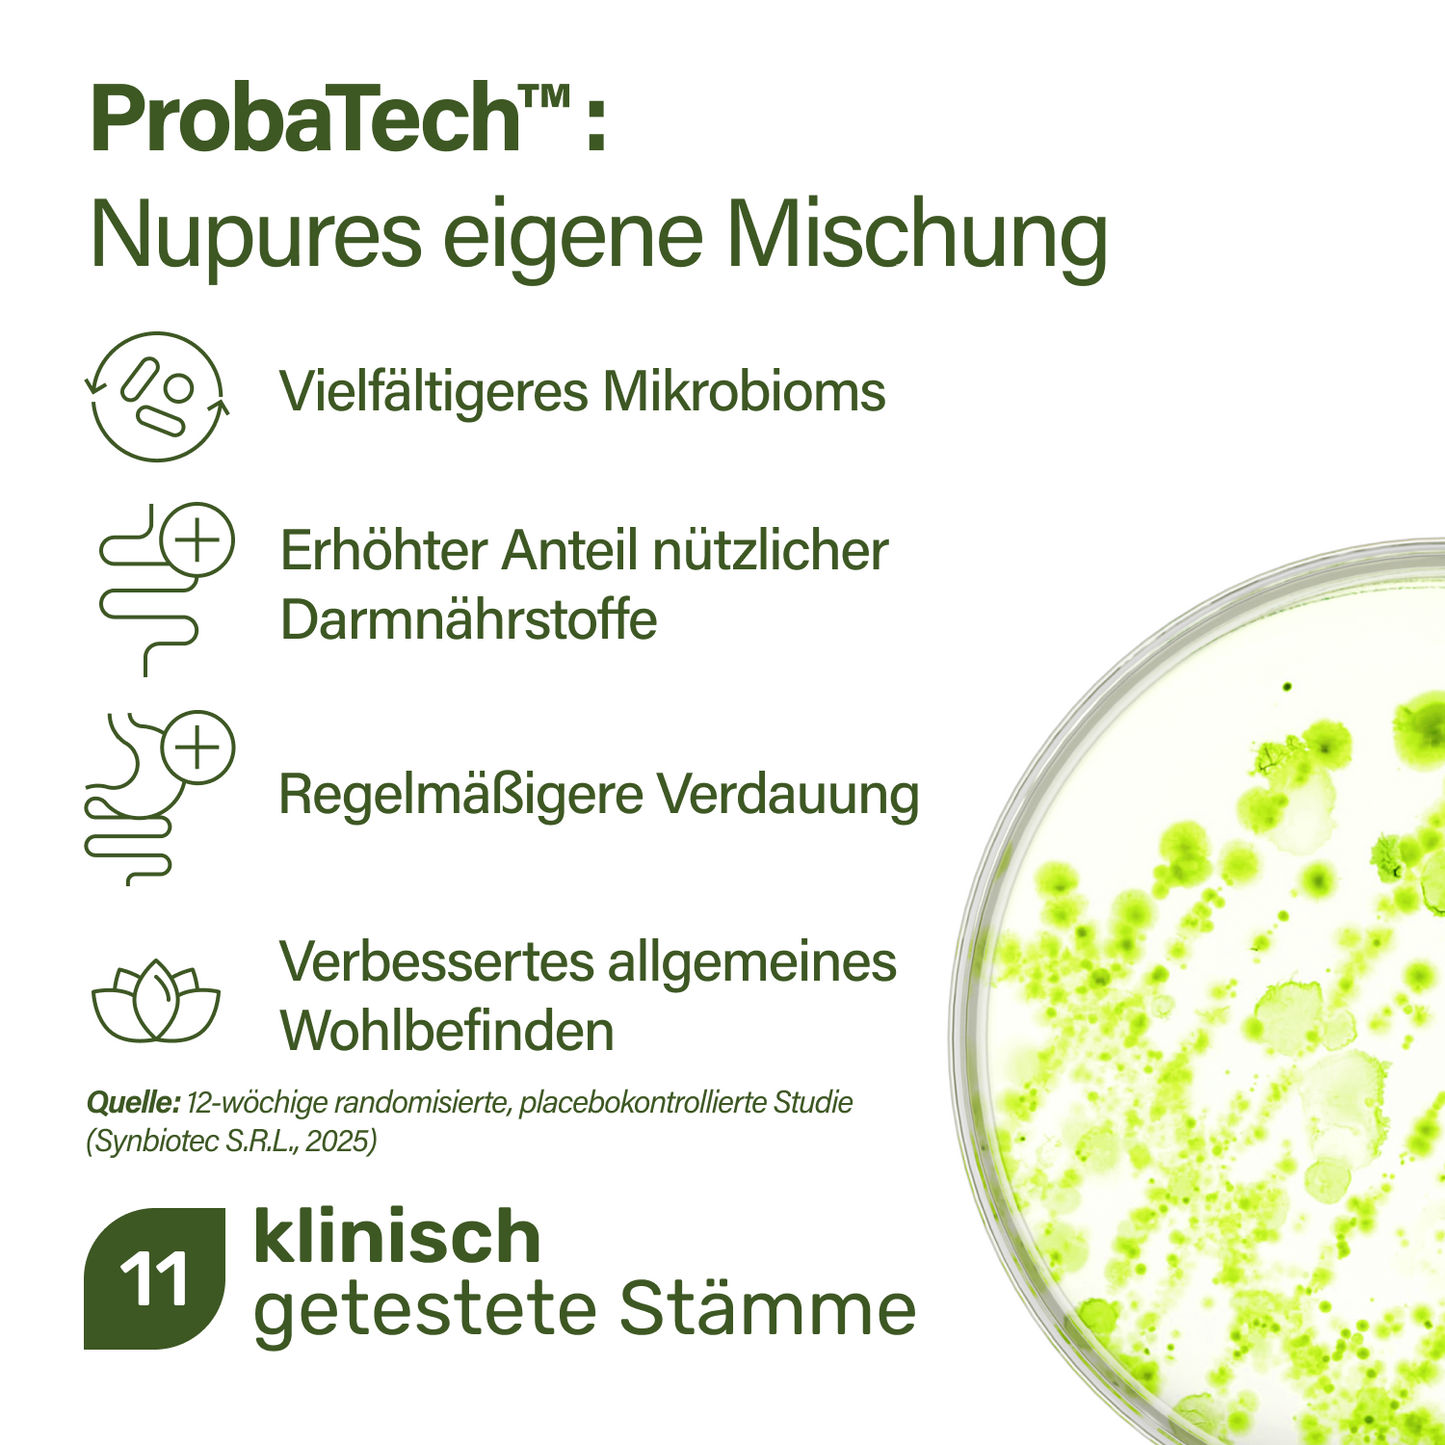
probaflor MAX SPEKTRUM N95 Pulver

probaflor MAX SPEKTRUM N95 Pulver
probaflor MAX SPEKTRUM N95 Pulver
Aktuell sehr beliebt!
Weltweit höchste Anzahl an Bakterienstämmen – jetzt im praktischen On-the-go-Format
- Breitspektrum 3-in-1 Komplett-Biotikum als Pulver
- Weltweit höchste Anzahl an Bakterienstämmen mit 95 wissenschaftlich untersuchten Kulturen
- Enthält Nupures eigene Kombination aus 11 klinisch geprüften Stämmen
- Ahmt die natürliche Vielfalt des Darmmikrobioms nach
- Garantierte Hochdosierung mit 20 Milliarden KBE pro Tagesportion – bis zum Ende der Haltbarkeit
- Unterstützt die Verdauung und trägt zum Erhalt einer gesunden Darmschleimhaut bei
- Fördert Verdauungskomfort, Regelmäßigkeit und reduziert Blähungen
- Erfrischender Zitronengeschmack – einfach in Wasser, Saft oder Joghurt einrühren
- 28 Sachets pro Packung
- Wissenschaftlich belegte StämmeWeltweit höchstes Spektrum an Stämmen zur Nachahmung der natürlichen Vielfalt des Darmmikrobioms - inklusive Nupure's eigenem Mix aus 11 klinisch geprüften Stämmen
- Mrd. KBE pro Tagesdosis600 Mrd KBE pro Gramm
 ProbaTech™Nupures eigene klinisch geprüfte Stammformel
ProbaTech™Nupures eigene klinisch geprüfte Stammformel
Entdecken Sie Ihre Probaflor-Variante:
Mehr kaufen, mehr sparen!




Verfügbarkeit für Abholungen konnte nicht geladen werden

Bezahlen nach 30 Tagen mit Klarna.
-
Gratis Versand ab € 30
-
Lieferzeit 1-2 Werktage
-
90-Tage-Geld-zurück-Garantie













probaflor MAX SPEKTRUM N95 Pulver
-
Ohne Gluten
-
Kein GMO
-
Ohne Zucker
-
Apotheken-Qualität
Einklappbarer Inhalt
Inhaltsstoffe
Natürliches Zitronenaroma; Chicorée (Cichorium intybus L.) Wurzelfaser (90 % Inulin); Zitronenfruchtpulver; Isomaltulose; Säureregulator: Zitronensäure; Bifidobacterium animalis spp. lactis Bi1; Bifidobacterium longum ES1 (hitzeinaktiviert); Süßungsmittel: Steviolglycoside aus Stevia (Steviol-Äquivalente: 2,2 mg/Sachet); Bakterienstämme [Bifidobacterium animalis spp. lactis Bi1, Lactobacillus paracasei IMC 502®, Bifidobacterium animalis spp. lactis BLC 1, Lactobacillus lactis Arten, Lactobacillus delbrueckii ssp. bulgaricus LB284, Lactobacillus paracasei LPC127, Lactobacillus paracasei LPC128, Lactobacillus helveticus LH102, Lactobacillus plantarum LP48, Lactobacillus paracasei BGP1, Lactobacillus paracasei BGP2, Lactobacillus paracasei LPC43, Lactobacillus rhamnosus LRH01, Lactobacillus rhamnosus LRH05, Lactobacillus rhamnosus LRH14, Lactobacillus rhamnosus LRH58, Lactobacillus curvatus LCV16, Lactobacillus sakei LSK14, Pediococcus acidilactici SP29, Pediococcus pentosaceus PP02, Streptococcus thermophilus ST628, Bifidobacterium bifidum SP9, Bifidobacterium breve Bl10, Bifidobacterium breve Bbr8, Bifidobacterium adolescentis SP77, Bifidobacterium longum SP54, Lactobacillus acidophilus LA3, Lactobacillus acidophilus LA1, Lactobacillus delbrueckii ssp. bulgaricus LB2, Lactobacillus buchneri LBC01, Lactobacillus brevis SP48, Lactobacillus casei BGP93, Lactobacillus crispatus SP28, Lactobacillus fermentum LF2, Lactobacillus fermentum CS57, Lactobacillus helveticus SP27, Lactobacillus delbrueckii ssp. lactis LL82, Lactobacillus plantarum BG112, Lactobacillus plantarum LB931, Lactobacillus plantarum 14D, Lactobacillus paracasei 101/37, Lactobacillus reuteri LR92, Lactobacillus rhamnosus SP1, Lactobacillus rhamnosus LB21, Lactobacillus rhamnosus IMC 501®, Lactobacillus rhamnosus LR1, Lactobacillus rhamnosus CA 15®, Lactobacillus salivarius SP28, Streptococcus thermophilus SP4, Streptococcus thermophilus Z57] (enthält Milch); Riboflavin.
Einnahmehinweis
Erwachsene nehmen täglich 1 Sachet in einem Glas Wasser (200 ml) aufgelöst ein."
Wichtige Hinweise
Die empfohlene Tagesdosis sollte nicht überschritten werden. Nahrungsergänzungsmittel sollten nicht als Ersatz für eine abwechslungsreiche und ausgewogene Ernährung und eine gesunde Lebensweise verwendet werden. Lagern Sie das Produkt vor Licht geschützt, kühl und trocken. Außerhalb der Reichweite von Kleinkindern aufbewahren.
Maximales Spektrum für ein diverses Mikrobiom

Unser Verdauungssystem beherbergt Hunderte verschiedener Bakterienarten und bildet damit ein komplexes Ökosystem – das sogenannte Darmmikrobiom. Diese Bakterien spielen eine zentrale Rolle für die Verdauung, das Immunsystem und das allgemeine Wohlbefinden.
Studien zeigen, dass ein breites bakterielles Spektrum die Funktion und Widerstandskraft des Mikrobioms verbessert. Verschiedene Stämme übernehmen unterschiedliche Aufgaben – fällt einer aus, können andere einspringen und so die Stabilität erhalten.
Mit 95 wissenschaftlich untersuchten Stämmen bietet es das weltweit umfassendste mikrobiotische Spektrum – jetzt auch im praktischen On-the-go-Format.
ProbaTech™ – klinisch geprüfte Grundlage

MAX SPEKTRUM N95 Sachets enthalten ProbaTech™ – eine proprietäre Kombination aus Milchsäurebakterienstämmen, die in einer 12-wöchigen, randomisierten, doppelblinden Studie an gesunden Erwachsenen klinisch untersucht wurden.
Die Studie zeigte eine verbesserte mikrobielle Diversität im Darm, einen Anstieg nützlicher Darmstoffe, eine regelmäßigere Verdauung sowie eine generelle Verbesserung der Lebensqualität. Diese wissenschaftlich geprüften Stämme bilden das Fundament von MAX SPEKTRUM N95 und tragen dazu bei, das mikrobielle Gleichgewicht, den Verdauungskomfort und das tägliche Wohlbefinden zu unterstützen.
Klinisch belegte Ergebnisse
-
2,9xstärkere Reduktion von Verdauungsbeschwerden
-
+35%Anstieg nützlicher Darmstoffe
-
5,3xDes Glückshormons Serotonin wird im Darm produziert.
Wie das MAX SPEKTRUM wirkt
- 1Chicorée-Wurzelfasern mit natürlichem Inulingehalt unterstützen die Verdauung, dienen als Nährstoffquelle für nützliche Darmbakterien und tragen zur normalen Funktion des Verdauungssystems bei.
- 2Vitamin B2 trägt zur Erhaltung der Darmschleimhaut bei – einer natürlichen Barriere im Verdauungstrakt und wichtig für Nährstoffaufnahme und Immunabwehr.

- 3ProbaTech™ enthält 11 wissenschaftlich ausgewählte Bakterienstämme, die klinisch im Hinblick auf mikrobielle Vielfalt, Verdauungskomfort und Regelmäßigkeit untersucht wurden.
- 4Die Formel enthält außerdem Bifidobacterium longum ES1 – ein wärmebehandelter Stamm, der klinisch auf seine positive Wirkung auf das Verdauungswohlbefinden und die Lebensqualität geprüft wurde.
Fachliche Einblicke mit Dr. Simon Hörster

"Ein gesundes Mikrobiom ist kein Zufallsprodukt, sondern das Resultat bewusster Entscheidungen – Tag für Tag. Ein fundiertes Verständnis, gesunde Routinen und passende Unterstützung mit vielfältigen lebenden Bakterienstämmen können die Darmgesundheit gezielt fördern – und damit das gesamte Wohlbefinden."
Dr. Simon Hörster
Internist, Gastroenterologe & Ernährungsmediziner
Unsere sorgfältig ausgewählten Stämme

FAQ
-
Was ist der Nutzen von 95 Bakterienstämmen?
Jeder Bakterienstamm hat eigene Eigenschaften und Funktionen im Darm. Durch die Kombination von 95 verschiedenen Stämmen bietet MAX SPEKTRUM N95 eine breite Unterstützung, die der natürlichen Vielfalt des Darmmikrobioms nachempfunden ist. Diese Vielfalt stärkt die Stabilität des Mikrobioms, unterstützt die Verdauung und trägt zur Darmgesundheit bei.
-
Wie wird MAX SPEKTRUM N95 eingenommen?
Den Inhalt eines Sachets in einem Glas Wasser (ca. 200 ml) auflösen, gut umrühren und einmal täglich trinken.
-
Wann ist der beste Zeitpunkt für die Einnahme?
Die Einnahme ist zu jeder Tageszeit möglich. Viele bevorzugen die Einnahme zu oder nach einer Mahlzeit – sie ist aber auch auf nüchternen Magen gut verträglich.
-
Kann das Produkt dauerhaft eingenommen werden?
Ja. MAX SPEKTRUM N95 ist für die tägliche und langfristige Einnahme geeignet.
-
Enthält das Produkt lebende Bakterienkulturen?
Ja. Jedes Sachet enthält 20 Milliarden lebende Kulturen aus 95 verschiedenen Stämmen – entwickelt, um die natürliche Vielfalt des Darmmikrobioms nachzubilden.
-
Ist MAX SPEKTRUM N95 für Vegetarier oder Veganer geeignet?
Nein. Das Produkt enthält Milch und ist daher nicht für Personen mit Milchallergie oder für eine vegane Ernährung geeignet.
-
Enthält das Produkt Zucker, Laktose oder Gluten?
MAX SPEKTRUM N95 ist frei von Gluten, zugesetztem Zucker und künstlichen Zusatzstoffen. Es enthält jedoch Milch und ist nicht laktosefrei.
-
Kann ich es zusammen mit anderen Nahrungsergänzungsmitteln einnehmen?
Ja, in der Regel ist eine gleichzeitige Einnahme unproblematisch. Wenn Sie Medikamente einnehmen oder unter einer Erkrankung leiden, sprechen Sie bitte mit Ihrem Arzt oder Ihrer Ärztin.
-
Kann ich MAX SPEKTRUM N95 während Schwangerschaft oder Stillzeit verwenden?
Als Vorsichtsmaßnahme wird die Einnahme während der Schwangerschaft oder Stillzeit nur nach Rücksprache mit dem Arzt oder der Hebamme empfohlen.
-
Ist MAX SPEKTRUM N95 auch auf Reisen oder bei unregelmäßigem Alltag geeignet?
Ja. Das Produkt ist stabil, einfach mitzunehmen und ideal für Zeiten mit wechselnden Routinen oder auf Reisen.
Ist gut angekommen alles perfekt
Ist leicht einzunehmen.
Im stressigen Alltag und schnellem Essen habe ich etwas gesucht, um meinen Darm zu entlasten und zu unterstützen.
Ich nehme probaflor Max Spektrum N95 nun seit etwa 2 Wochen und kann auf jeden Fall schon eine Verbesserung feststellen.
Ich fühle mich fitter und allgemein wohler.
Nach 3 Tagen Einnahme merke ich einen Rückgang der Heißhungerattacken.
Ich nehm sie jetzt seit ca 1 Woche und es geht mir soooooo gut. Ich hab keinen aufgeblähten Bauch mehr fühl mich auch sonst nicht mehr so träge.
Ich hab es schon weiterempfohlen und werde mir noch mind 1. Packung holen.

Wie können wir Ihnen helfen?
-
 E-Mail an info@nupureshop.com
E-Mail an info@nupureshop.com -
 Anruf unter +49 (0)8276 5187790
Anruf unter +49 (0)8276 5187790 -
WhatsApp: +49 (0)8276 9099967
Bleiben Sie auf dem Laufenden
Exklusive Sonderangebote, Produkteinführungen sowie die neuesten wissenschaftlichen Erkenntnisse stets in Ihrem Posteingang.

probaflor MAX SPEKTRUM N95 Pulver
- Wenn du dich für eine Auswahl entscheidest, wird die Seite komplett aktualisiert.
- Wird in einem neuen Fenster geöffnet.